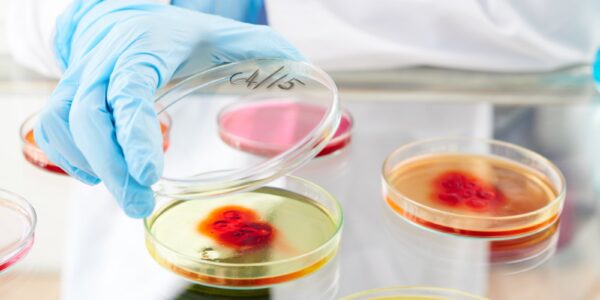

Od „Kolejorza” do „Wojskowych” – piłkarskie tożsamości Poznania i Warszawy
Polska piłka nożna to nie tylko mecze, transfery i trofea – to także głęboko zakorzenione tożsamości kibicowskie, które kształtują sposób, w jaki całe miasta patrzą na futbol. Poznań i Warszawa, choć dzieli je nieco ponad 300 kilometrów, funkcjonują w piłkarskiej…
Czas – czy to tylko iluzja? Fizyka i filozofia jednego z największych pytań nauki
Czas to jedno z najbardziej podstawowych i jednocześnie zagadkowych pojęć w nauce. Codziennie go doświadczamy – mierzymy minuty, godziny, dni – ale wciąż nie mamy jednej, spójnej definicji tego, czym jest. Czy czas rzeczywiście „płynie”, jak zwykło się uważać, czy…
Czym są symulacje komputerowe i jak wspierają badania naukowe?
Współczesna nauka coraz częściej przenosi eksperymenty z rzeczywistości fizycznej do świata wirtualnego. Symulacje komputerowe pozwalają modelować zjawiska, które trudno lub wręcz niemożliwe byłoby zbadać tradycyjnymi metodami. Dzięki potężnym komputerom i coraz doskonalszym algorytmom, naukowcy mogą przewidywać zachowania cząsteczek, projektować nowe…
Jak mądrze rozmawiać z młodzieżą o polityce i demokracji?
„Polityka? To nie dla mnie” — to jedno z najczęściej powtarzanych zdań przez młodych ludzi, kiedy temat rozmowy schodzi na wybory, partie, rząd. Czasem wynika to z dystansu, czasem z braku wiedzy, a nierzadko z przekonania, że głos młodego człowieka…
Technologia CRISPR – rewolucja w edycji genów
CRISPR (Clustered Regularly Interspaced Short Palindromic Repeats) to technologia edycji genów, która w ostatnich latach zrewolucjonizowała biotechnologię. Jej działanie opiera się na systemie immunologicznym bakterii, które wykorzystują cząsteczki RNA oraz enzymy (najczęściej Cas9), aby przeciwdziałać infekcjom wirusowym. Naukowcy opracowali metodę,…
Godła: symbol państwa i narodu
Godło państwowe to jeden z najważniejszych symboli każdego narodu. Reprezentuje jego historię, tradycje, wartości i aspiracje. Jest to znak rozpoznawczy, który identyfikuje państwo na arenie międzynarodowej i jednoczy jego obywateli. W tym artykule przyjrzymy się bliżej roli i znaczeniu godła,…
Neuroestetyka – jak mózg odbiera piękno?
Choć sztuka i nauka przez wieki rozwijały się pozornie w odrębnych światach, w XXI wieku coraz częściej się spotykają. Neuroestetyka to dziedzina, która bada, w jaki sposób nasz mózg reaguje na dzieła sztuki, kształty, kolory czy dźwięki. To połączenie neuronauki,…
Jak działa pamięć? Odkrycia z pogranicza neurobiologii i psychologii
Bez pamięci nie bylibyśmy w stanie uczyć się, planować, rozpoznawać bliskich czy nawet utrzymać spójnego obrazu własnego „ja”. To ona tworzy ciągłość naszego życia, przechowuje wspomnienia i kieruje naszym zachowaniem. Choć pamięć często utożsamiana jest z prostym zapamiętywaniem faktów, w…
Komórki macierzyste – nadzieja współczesnej medycyny
Komórki macierzyste od kilku dekad fascynują środowisko naukowe i medyczne. Ich unikalna zdolność do przekształcania się w różne typy komórek ciała sprawia, że są postrzegane jako przyszłość terapii regeneracyjnych. W odróżnieniu od dojrzałych komórek organizmu, komórki macierzyste potrafią nie tylko…
Przyszłość oceanów – jak nauka walczy o życie pod wodą
Oceany pokrywają ponad 70% powierzchni Ziemi i odpowiadają za produkcję co najmniej połowy tlenu, którym oddychamy. To nie tylko przestrzeń życiowa dla milionów gatunków, ale również kluczowy element globalnego systemu klimatycznego. Niestety, w ostatnich dekadach środowisko wodne zaczęło dramatycznie się…
Czym są fraktale i dlaczego występują w naturze?
Fraktale to struktury, które wykazują samopodobieństwo – oznacza to, że ich fragmenty są podobne do całości, niezależnie od skali powiększenia. Choć ich idea narodziła się w matematyce, zaskakująco często można je dostrzec w naturze. Paprocie, płatki śniegu, systemy naczyń krwionośnych…
Plan + strategia + korepetycje: jak skutecznie uczyć się do matury z Więcej niż Matura
Efektywna nauka do matury nie polega tylko na „przerabianiu” materiału. Liczy się plan, świadomość błędów i odpowiednie wsparcie. Zobacz, jak uniknąć 19 najczęstszych problemów i jak dzięki metodzie UNIPLAN oraz platformie Więcej niż Matura podejść do egzaminów z biol-chemu i…